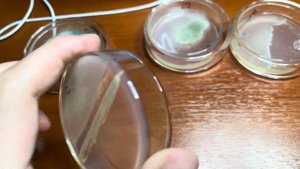

2:41
2:41
2023-12-20 15:29

 11:55
11:55

 11:55
11:55
2024-10-16 17:37

 5:34
5:34

 5:34
5:34
2023-11-14 23:21

 5:57
5:57
5:57
5:57
2024-04-23 03:33

 14:17
14:17

 14:17
14:17
2025-04-28 08:45

 20:48
20:48

 20:48
20:48
2023-11-18 07:30

 4:45
4:45

 4:45
4:45
2023-11-17 15:09

 1:13
1:13

 1:13
1:13
2024-08-30 02:24

 1:23
1:23

 1:23
1:23
2024-10-15 12:51

 1:33
1:33

 1:33
1:33
2025-05-19 16:50

 2:37
2:37

 2:37
2:37
2024-04-12 12:40

 3:33
3:33

 3:33
3:33
2022-03-16 14:08

 11:34
11:34

 11:34
11:34
2022-03-24 00:45

 1:04:31
1:04:31

 1:04:31
1:04:31
2021-07-12 02:24

 9:47
9:47

 9:47
9:47
2023-09-26 10:22

 1:12:03
1:12:03

 1:12:03
1:12:03
2023-02-12 21:32

 1:28:48
1:28:48

 1:28:48
1:28:48
2023-08-15 14:38

 1:06:32
1:06:32
![Азиз Абдуллох - Аллохнинг айтгани булади (Премьера клипа 2025)]() 3:40
3:40
![MARSO - Дура (Премьера клипа 2025)]() 3:05
3:05
![Magas - Без тебя (Премьера клипа 2025)]() 2:28
2:28
![INSTASAMKA - AGENT GIRL (Премьера клипа 2025)]() 3:24
3:24
![Мария Зайцева - Жаль моя (Премьера клипа 2025)]() 4:25
4:25
![SERYABKINA, Брутто - Светофоры (Премьера клипа 2025)]() 3:49
3:49
![ИЮЛА - Ты был прав (Премьера клипа 2025)]() 2:21
2:21
![МАРАТ & АРНИ - Стала женой (Премьера клипа 2025)]() 3:51
3:51
![Сардор Расулов - Етолмадим (Премьера клипа 2025)]() 4:15
4:15
![Игорь Крутой - Зонтик (Премьера клипа 2025)]() 4:00
4:00
![Рейсан Магомедкеримов - Забываю (Премьера клипа 2025)]() 3:20
3:20
![Рустам Батербиев - Пора расстаться (Премьера клипа 2025)]() 2:38
2:38
![Сергей Сухачёв - Розовый туман (Премьера клипа 2025)]() 3:13
3:13
![Аля Вайш - По кругу (Премьера клипа 2025)]() 2:37
2:37
![Джатдай - Забери печаль (Премьера клипа 2025)]() 2:29
2:29
![Любовь Попова - Прощай (Премьера клипа 2025)]() 3:44
3:44
![Зара - Я несла свою беду (Премьера клипа 2025)]() 3:36
3:36
![Олег Семенов - Бархатный сезон (Премьера клипа 2025)]() 3:51
3:51
![Руслан Гасанов, Роман Ткаченко - Друзьям (Премьера клипа 2025)]() 3:20
3:20
![Зафар Эргашов - Мусофирда каридим (Премьера клипа 2025)]() 4:58
4:58
![Любимец женщин | Roger Dodger (2002)]() 1:41:29
1:41:29
![Я видел свет | I Saw the Light (2015)]() 2:03:50
2:03:50
![Обитель | The Home (2025)]() 1:34:43
1:34:43
![Храброе сердце | Braveheart (1995)]() 2:57:46
2:57:46
![Хани, не надо! | Honey Don't! (2025)]() 1:29:32
1:29:32
![Псы войны | Hounds of War (2024)]() 1:34:38
1:34:38
![Терминатор 2: Судный день | Terminator 2: Judgment Day (1991) (Гоблин)]() 2:36:13
2:36:13
![Четверо похорон и одна свадьба | Plots with a View (2002)]() 1:32:52
1:32:52
![Супруги Роуз | The Roses (2025)]() 1:45:29
1:45:29
![Сверху вниз | Highest 2 Lowest (2025)]() 2:13:21
2:13:21
![Только ты | All of You (2025)]() 1:38:22
1:38:22
![Плохие парни 2 | The Bad Guys 2 (2025)]() 1:43:51
1:43:51
![Чумовая пятница 2 | Freakier Friday (2025)]() 1:50:38
1:50:38
![Никто 2 | Nobody 2 (2025)]() 1:29:27
1:29:27
![F1 (2025)]() 2:35:53
2:35:53
![Свинтусы | The Twits (2025)]() 1:42:50
1:42:50
![Непрощённая | The Unforgivable (2021)]() 1:54:10
1:54:10
![Диспетчер | Relay (2025)]() 1:51:56
1:51:56
![Эффект бабочки | The Butterfly Effect (2003)]() 1:53:35
1:53:35
![Вечеринка только начинается | The Party's Just Beginning (2018)]() 1:31:20
1:31:20
![Пакман в мире привидений]() 21:37
21:37
![Енотки]() 7:04
7:04
![Корги по имени Моко. Домашние животные]() 1:13
1:13
![Чуч-Мяуч]() 7:04
7:04
![Сборники «Умка»]() 1:20:52
1:20:52
![Корги по имени Моко. Защитники планеты]() 4:33
4:33
![Сборники «Ну, погоди!»]() 1:10:01
1:10:01
![МиниФорс]() 0:00
0:00
![Паровозик Титипо]() 13:42
13:42
![Забавные медвежата]() 13:00
13:00
![Пиратская школа]() 11:06
11:06
![Таинственные золотые города]() 23:04
23:04
![Псэмми. Пять детей и волшебство Сезон 1]() 12:17
12:17
![Умка]() 7:11
7:11
![Артур и дети круглого стола]() 11:22
11:22
![Врумиз. 1 сезон]() 13:10
13:10
![МиниФорс Сезон 1]() 13:12
13:12
![Лудлвилль]() 7:09
7:09
![Отряд А. Игрушки-спасатели]() 13:06
13:06
![Игрушечный полицейский Сезон 1]() 7:19
7:19

 1:06:32
1:06:32Скачать видео
| 256x144 | ||
| 640x360 | ||
| 1280x720 |
 3:40
3:40
2025-10-18 10:34
 3:05
3:05
2025-10-17 11:37
 2:28
2:28
2025-10-17 12:00
 3:24
3:24
2025-10-17 11:33
 4:25
4:25
2025-10-17 11:28
 3:49
3:49
2025-10-25 12:52
 2:21
2:21
2025-10-18 10:16
 3:51
3:51
2025-10-16 11:41
 4:15
4:15
2025-10-26 12:52
 4:00
4:00
2025-10-18 10:19
 3:20
3:20
2025-10-16 11:19
 2:38
2:38
2025-10-16 11:06
 3:13
3:13
2025-10-24 12:18
 2:37
2:37
2025-10-23 11:33
 2:29
2:29
2025-10-24 11:25
 3:44
3:44
2025-10-21 09:25
 3:36
3:36
2025-10-18 10:07
 3:51
3:51
2025-10-16 10:57
 3:20
3:20
2025-10-25 12:59
 4:58
4:58
2025-10-18 10:31
0/0
 1:41:29
1:41:29
2025-08-15 19:31
 2:03:50
2:03:50
2025-08-15 19:31
 1:34:43
1:34:43
2025-09-09 12:49
 2:57:46
2:57:46
2025-08-31 01:03
 1:29:32
1:29:32
2025-09-15 11:39
 1:34:38
1:34:38
2025-08-28 15:32
 2:36:13
2:36:13
2025-10-07 09:27
 1:32:52
1:32:52
2025-08-15 19:31
 1:45:29
1:45:29
2025-10-23 18:26
 2:13:21
2:13:21
2025-09-09 12:49
 1:38:22
1:38:22
2025-10-01 12:16
 1:43:51
1:43:51
2025-08-26 16:18
 1:50:38
1:50:38
2025-10-16 16:08
 1:29:27
1:29:27
2025-09-07 22:44
 2:35:53
2:35:53
2025-08-26 11:45
 1:42:50
1:42:50
2025-10-21 16:19
 1:54:10
1:54:10
2025-08-27 17:17
 1:51:56
1:51:56
2025-09-24 11:35
 1:53:35
1:53:35
2025-09-11 08:20
 1:31:20
1:31:20
2025-08-27 17:17
0/0
 21:37
21:37
2024-11-28 17:35
 7:04
7:04
2022-03-29 18:22
 1:13
1:13
2024-11-29 14:40
 7:04
7:04
2022-03-29 15:20
 1:20:52
1:20:52
2025-09-19 17:54
 4:33
4:33
2024-12-17 16:56
 1:10:01
1:10:01
2025-07-25 20:16
 0:00
0:00
2025-10-28 03:45
 13:42
13:42
2024-11-28 14:12
 13:00
13:00
2024-12-02 13:15
 11:06
11:06
2022-04-01 15:56
 23:04
23:04
2025-01-09 17:26
2021-09-22 22:23
 7:11
7:11
2025-01-13 11:05
 11:22
11:22
2023-05-11 14:51
2021-09-24 16:00
2021-09-23 00:15
 7:09
7:09
2023-07-06 19:20
 13:06
13:06
2024-11-28 16:30
2021-09-22 21:03
0/0

